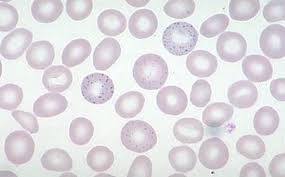

What is orthopnea
SOB while lying flat
What is the only cardiac abnormality that INCREASES with valsalva maneuver
What is pleiotropy
When one gene mutations contributes to multiple phenotypic effects, often in different organ systems
What is effect modification
What is relative risk and its equation?
What is odds ratio and its equation
Occlusion of what artery will cause Wernicke’s aphasia?
Middle cerebral
Occlusion of what artery will cause Broca’s aphasia?
Middle cerebral
What dietary substance other than fructose should be avoided in aldolase B deficiency?
Sucrose (disaccharide that breaks down into fructose)
In what 3 steps of the citric acid cycle is ribaflavin (B2) necessary?
Pyruvate dehydrogenase (TLCFN)
Alpha-ketoglutarate dehydrogenase (TLCFN)
Succinate dehydrogenase (FAD –> FADH2)
What is the sublingual drug given to patients with angina
Nitroglycerin
What are the symptoms of Gerstmann Syndrome
What is the MOA of phenelzine
Sketchy = wine funnel
What is the main characteristic of atypical depression
What disorders are associated with basophilic stippling
Describe the function of Dynein and Kinesin
MOA of Polyethylene glycol
Osmotic laxative
MOA of Psyllium
MOA of Docusate
What is Meniere disease
Describe presentation of Vestibular neuritis
Is HLA-DR3 and HLA-DR4 associated with Type I or Type II DM
Type I DM
MRI findings in multiple sclerosis
Periventricular plaques (areas of oligodendrocyte loss and reactive gliosis)

Describe the MOA of glucagon as a treatment for beta blocker toxiciy
\